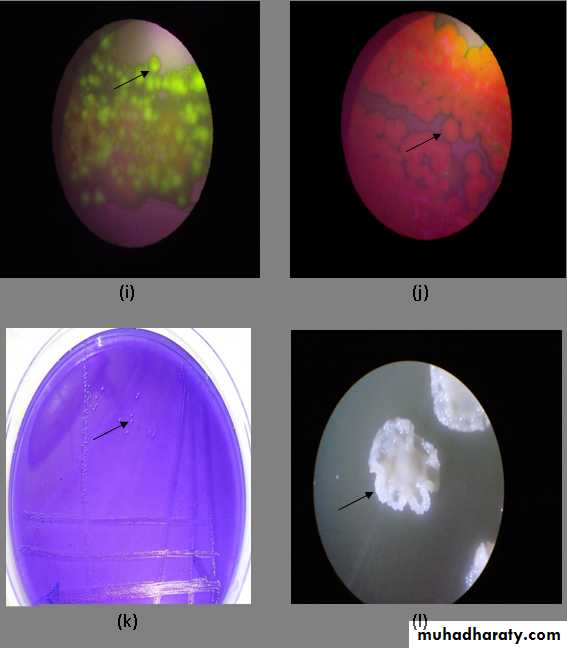
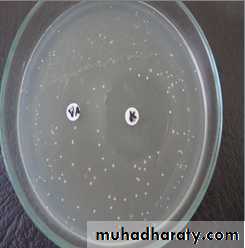

Lactobacillus
Characteristics
Gram-positive coccobacilli non spore formingα- or non-haemolytic, facultative anaerobes.
ferment carbohydrates to form acids (i.e. acidogenic) and tolerate acid( i.e. aciduric).taxonomy of lactobacilli
Lactobactobacilli either :1- homofermenters, which produce mainly lactic acid (65%) from glucose fermentation (e.g. Lactobacillus casei)
2- heterofermenters, which produce lactic acid as well as acetate, ethanol and carbon dioxide (e.g. Lactobacillus fermentum).
L. casei and Lactobacillus rhamnosus, Lactobacillus acidophilus and the newly described species, Lactobacillus oris, are common in the oral cavity.
Habitat
the oral cavity ( constitute less than 1% of the total flora).gastrointestinal tract (has a role maintaining the homoeostasis of the intestinal flora and ‘lactobacillus-laced’ food have gained popularity among the health-conscious public
female genital tract (major constituents of the vaginal flora and help maintain its low pH equilibrium).
Lactobacilli are saprophytes in vegetable and animal material (e.g. milk).
Culture and identification
Lactobacilli microaerophilic grow in the presence of carbon dioxide ,acidic pH (6.0).Media enriched with glucose or blood promote growth.
A special selective medium, tomato juice agar (pH 5.0), promotes the growth of Lactobacilli &suppressing other.
Identification is by biochemical reactions.
Pathogenicityfrequently isolated from deep carious lesions ( DEJ) where the pH tends to be acidic. Indeed lactobacilli were considered the main cariogenic agent (a theory disproved)
the number of lactobacilli in saliva taken as an indication of caries activity. (not very reliable)
useful for monitoring the dietary profile the level of lactobacilli correlates well with the intake of dietary carbohydrate.
The role of lactobacilli
Lactobacilli were previously believed to be the causative agents of dental cariesOn the negative side lactobacilli are rarely isolated from plaque before the development of caries and they are often absent from incipient lesions.
It is believed that:
• they are involved more in the progression of the deep enamel lesion (rather than the initiation)
• they are the pioneer organisms in the advancing front of the carious process, especially in dentine.
They were considered to be candidate organisms for caries because of
• their high numbers in most carious lesions• the positive correlation between their numbers in plaque and saliva and caries activity
• their ability to grow in low-pH environments (below pH 5) and to produce lactic acid
• their ability to synthesize both ex.& intra cellular polysaccharides from sucrose
• the ability of some strains to produce caries in gnotobiotic (germ-free) rats
• their numbers in dental plaque in healthy sites are usually low.
Fusobacteria
Gram –ve , non-sporing, anaerobic, non-motile, non- or weakly fermentativespindle-shaped bacilli (with fused ends: hence the name).
They are normal inhabitants of the oral cavity, colon and female genital tract and are sometimes isolated from pulmonary and pelvic abscesses.
Fusobacteria Species
Fusobacterium nucleatum
Fusobacterium periodontium
Fusobacterium simiae are isolated mainly from periodontal disease sites,
Fusobacterium alocis
Fusobacterium sulci are sometimes found in the healthy gingival sulcus.
Non-oral species include
Fusobacterium gonidiaformans
Fusobacterium russii
Fusobacterium ulcerans.
Fusobacterium nucleatum
Habitat and transmission
Several subspecies of F. nucleatum have been identified in different habitats.F. nucleatum subsp. polymorphum, found in the healthy gingival crevice
F. nucleatum subsp. nucleatum, recovered mainly from periodontal pockets
F. nucleatum subsp. vincentii. Infections are almost invariably endogenous.
Characteristics
Gram-negative
strictly anaerobic
cigar-shaped bacilli with pointed ends Cells often have a central swelling.
Grows on blood agar
Proteolytic
Bridge organism( secondary colonizer)
Associated with halitosis
Bacteria
identificationAnaerobic culture
Gram stain
Fluorescent microscope
identification. Biochemical reactions and the acidic end products of carbohydrate metabolism help
PCR
Antibiogram
Fluoresces chartreuse of Fusobacterium spp. under low Power fluorescent microscope
Sensitivity to kanamycin on Müller Hinton Agar of Fusobacterium spp
Pathogenicity
The endotoxin of the organism appears to be involved in the pathogenesis of periodontal disease( bone resorption). It possesses remarkable adherence propertiesfusobacterium adhesin A (FadA), which confers adherence.
As fusobacteria co-aggregate with most other oral bacteria, they are believed to be important bridging organisms between early and late colonizers during plaque formation
As fusobacteria can remove sulphur from cysteine and methionine to produce odoriferous hydrogen sulphide and methylmercaptan, they are thought to be associated with halitosis.
Biofilm Formation
Pathogenicity
F. nucleatum is usually isolated from polymicrobial infections; it is rarely the sole pathogen.In combination with oral spirochaetes (Treponema vincentii and others), it causes the classic fusospirochaetal infections
fusospirochaetal infections
acute (necrotizing) ulcerative gingivitis • Vincent’s angina, an ulcerative tonsillitis causing tissue necrosis, often due to extension of acute ulcerative gingivitis
• cancrum oris or noma: a sequel of acute ulcerative gingivitis with resultant gross tissue loss of the facial region (trench mouth).
trench mouth
Aetiology The main predisposing factors of ANUG are• poor oral hygiene
• severe malnutrition
• heavy smoking
• emotional stress
• primary herpetic gingivostomatitis
• acquired immunosuppression, such as recent measles infection
• infection with HIV
etiology
Antibiotic sensitivity and prevention
Fusobacteria are uniformly sensitive to penicillin and, being strict anaerobes, are sensitive to metronidazole.Regular oral hygiene and antiseptic mouth washes are the key for prevention of oral fusobacterial infections in susceptible individuals.